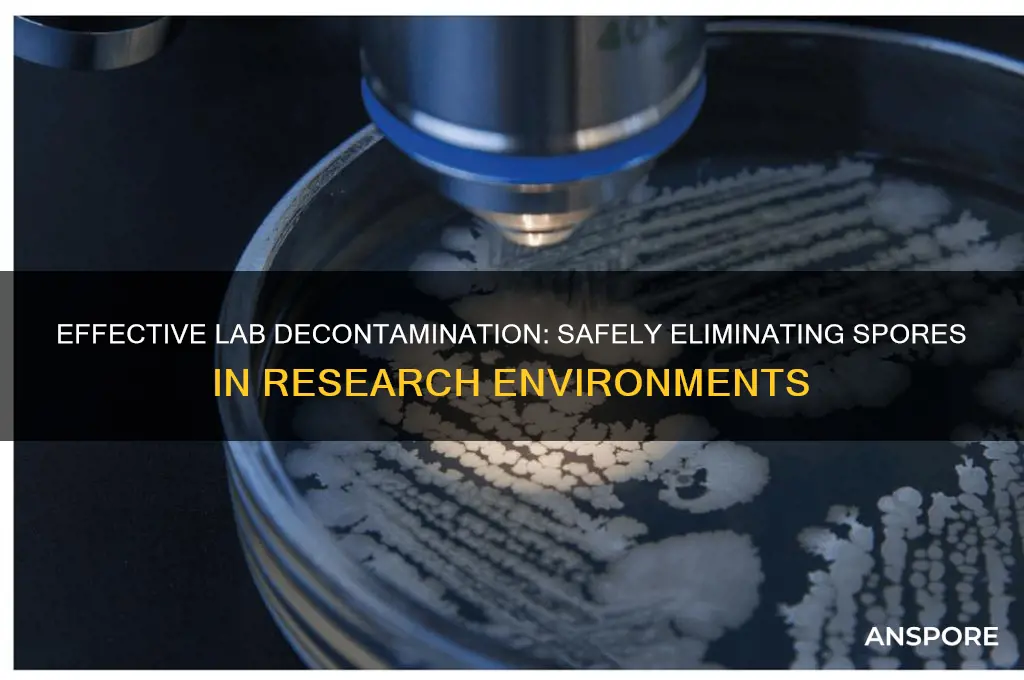
how to decontaminate spores in lab

Decontaminating spores in a laboratory setting is a critical process to ensure the safety of personnel and the integrity of experimental results, as spores are highly resistant to standard disinfection methods. Effective decontamination typically involves a combination of physical and chemical treatments, such as autoclaving at high temperatures and pressures, exposure to strong oxidizing agents like hydrogen peroxide or bleach, or the use of specialized sporicides. Proper containment, personal protective equipment, and adherence to biosafety protocols are essential to prevent spore dissemination during the decontamination process. Additionally, validation of decontamination methods through spore testing, such as the use of Bacillus atrophaeus or Geobacillus stearothermophilus indicators, is crucial to confirm the efficacy of the procedure.
| Characteristics | Values |
|---|---|
| Methods | Autoclaving, Chemical Disinfection, Dry Heat Sterilization, Irradiation, Filtration |
| Autoclaving Conditions | 121°C for 15-30 minutes at 15 psi (saturated steam) |
| Chemical Agents | Hydrogen Peroxide (H₂O₂), Bleach (Sodium Hypochlorite), Peracetic Acid, Ethanol |
| Hydrogen Peroxide Concentration | 6-30% (v/v) depending on application |
| Bleach Concentration | 5-10% (v/v) sodium hypochlorite |
| Dry Heat Temperature | 160-170°C for 2-4 hours |
| Irradiation Type | Gamma Radiation, UV Radiation |
| Gamma Radiation Dose | 2-10 kGy |
| UV Radiation Wavelength | 254 nm |
| Filtration Pore Size | 0.22 μm or smaller |
| Surface Decontamination | Wipe surfaces with 70% ethanol or 10% bleach solution |
| Personal Protective Equipment | Gloves, lab coat, goggles, face shield (when handling chemicals or irradiation sources) |
| Waste Disposal | Autoclaved or chemically treated waste should be disposed of according to local regulations |
| Validation Methods | Biological Indicators (e.g., Geobacillus stearothermophilus spores) |
| Safety Precautions | Ensure proper ventilation, avoid skin contact with chemicals, follow lab safety protocols |
| Effectiveness | Depends on method, concentration, and exposure time; spores are highly resistant |
| Applications | Laboratory equipment, surfaces, liquids, and waste decontamination |
Explore related products
What You'll Learn
- Chemical Decontamination Methods: Using sterilants like bleach, hydrogen peroxide, or ethanol for spore inactivation
- Autoclaving Techniques: High-pressure steam sterilization to effectively kill spores in lab equipment
- Filtration Protocols: Removing spores from liquids or air using sterile filters
- UV Radiation Application: Utilizing UV light to damage spore DNA and prevent replication
- Incineration Procedures: Burning contaminated materials to completely destroy spores and prevent spread

Chemical Decontamination Methods: Using sterilants like bleach, hydrogen peroxide, or ethanol for spore inactivation
Chemical decontamination of spores in a laboratory setting demands precision and efficacy, as spores are notoriously resistant to standard disinfection methods. Among the most effective agents for spore inactivation are bleach, hydrogen peroxide, and ethanol, each with unique mechanisms and application considerations. Bleach, a common household sterilant, is particularly potent due to its oxidizing properties, which disrupt spore coat proteins and nucleic acids. A 5–10% sodium hypochlorite solution, applied for 10–30 minutes, is typically sufficient for surface decontamination, though thorough rinsing is essential to prevent corrosion or residue. However, bleach’s reactivity with organic matter can reduce its efficacy, making it less ideal for complex environments.
Hydrogen peroxide, in contrast, offers a broader spectrum of action and is less corrosive than bleach. Its ability to penetrate spore coats and generate reactive oxygen species makes it highly effective for spore inactivation. Concentrations of 6–30% are commonly used, with vaporized hydrogen peroxide (VHP) systems providing a convenient method for large-scale decontamination. VHP is particularly useful in enclosed spaces like biosafety cabinets or entire rooms, where it achieves uniform coverage without physical contact. For liquid applications, a 3% solution can be effective when combined with prolonged exposure times, though higher concentrations are often preferred for rapid results.
Ethanol, while widely used for general disinfection, is less effective against spores compared to bleach or hydrogen peroxide. Its primary mechanism involves denaturing proteins and dissolving lipids, which are less impactful on the robust spore structure. However, ethanol’s rapid evaporation and low toxicity make it a practical choice for quick surface disinfection in less critical scenarios. A 70% solution is standard, but even at this concentration, complete spore inactivation may require extended contact times or repeated applications. For more reliable results, ethanol is often used in conjunction with other sterilants or mechanical methods like autoclaving.
When selecting a chemical sterilant, consider the specific requirements of your lab environment, including material compatibility, safety, and the level of contamination. Bleach is cost-effective but requires careful handling due to its corrosive nature. Hydrogen peroxide provides superior efficacy and safety, especially in vaporized form, but may be more expensive. Ethanol is convenient for routine disinfection but falls short against highly resistant spores. Always follow manufacturer guidelines for concentrations and exposure times, and ensure proper ventilation and personal protective equipment (PPE) when handling these chemicals. Combining chemical methods with physical decontamination techniques, such as heat or filtration, can further enhance spore inactivation and ensure a sterile laboratory environment.
Can Vinegar Effectively Kill C. Diff Spores? Facts and Myths
You may want to see also

Autoclaving Techniques: High-pressure steam sterilization to effectively kill spores in lab equipment
Spores, with their remarkable resistance to heat, chemicals, and radiation, pose a significant challenge in laboratory decontamination. Autoclaving, a cornerstone technique in microbiology, harnesses the power of high-pressure steam to effectively eradicate these resilient organisms from lab equipment. This method relies on a combination of elevated temperature (typically 121°C or 250°F) and prolonged exposure time (usually 15-30 minutes) to denature spore proteins and disrupt their cellular structures.
Understanding the Autoclave Cycle:
The autoclaving process involves a carefully orchestrated sequence of stages. It begins with conditioning, where the chamber is heated to remove air, ensuring steam can penetrate all surfaces. This is followed by the exposure phase, where the high-pressure steam maintains the target temperature for the specified duration. Finally, exhaust allows for controlled cooling and pressure release, preventing equipment damage.
Optimizing Autoclave Efficiency:
Several factors influence autoclave effectiveness. Load size and arrangement are crucial; overcrowding can hinder steam penetration. Proper packaging using autoclave-safe materials like polypropylene or Tyvek allows steam to reach all surfaces while containing contaminants. Monitoring with biological indicators, such as spore strips, provides definitive proof of sterilization success.
Practical Considerations:
While autoclaving is highly effective, it's not suitable for all materials. Heat-sensitive items like certain plastics, electronics, or flammable liquids require alternative methods. Regular maintenance of the autoclave, including cleaning and calibration, is essential for consistent performance. Additionally, safety precautions must be strictly followed, including wearing appropriate personal protective equipment and allowing adequate cooling time before handling sterilized materials.
Autoclaving remains a gold standard for spore decontamination in laboratories due to its reliability and efficacy. By understanding the principles, optimizing parameters, and adhering to safety guidelines, researchers can ensure a sterile environment for their experiments, minimizing the risk of contamination and promoting accurate results.
Mold Spores vs. Bacteria: Understanding the Key Differences and Similarities
You may want to see also

Filtration Protocols: Removing spores from liquids or air using sterile filters
Spores, with their resilient nature, pose a significant challenge in laboratory settings, particularly when dealing with liquids and air. Filtration protocols emerge as a critical tool in this battle, offering a physical barrier to trap these microscopic survivors.
Imagine a fine mesh, its pores meticulously sized to allow the passage of liquid or air while capturing spores, effectively removing them from the medium. This is the essence of filtration, a process both elegant in its simplicity and powerful in its application.
Sterile filters, the heroes of this story, come in various forms, each tailored to specific needs. For liquids, syringe filters with pore sizes of 0.22 microns or smaller are commonly employed. These filters, often made of materials like polyethersulfone (PES) or nylon, provide a robust barrier against spores while allowing efficient flow of the liquid.
Air filtration demands a different approach. High-efficiency particulate air (HEPA) filters, with their intricate web of fibers, are the gold standard. These filters, capable of capturing particles as small as 0.3 microns with an efficiency of 99.97%, are essential for maintaining sterile environments in laminar flow hoods and biosafety cabinets.
The process itself is straightforward yet demands precision. For liquid filtration, the sample is drawn into a syringe and slowly pushed through the filter. Care must be taken to avoid clogging, especially with viscous liquids. Air filtration is a continuous process, with air drawn through the HEPA filter, ensuring a constant supply of sterile air.
Regular filter changes are paramount. Over time, filters become saturated with trapped particles, reducing their efficiency. Manufacturers provide guidelines for filter lifespan, but factors like the level of contamination and the nature of the filtered material can necessitate more frequent changes.
While filtration is a powerful tool, it's not without limitations. Some spores, due to their small size or unique characteristics, may slip through even the finest filters. Additionally, filtration can be time-consuming, particularly for large volumes. Therefore, it's often used in conjunction with other decontamination methods, such as autoclaving or chemical treatment, to achieve comprehensive spore removal.
In the intricate dance of laboratory work, where precision and sterility are paramount, filtration protocols stand as a reliable partner. By understanding the principles, selecting the appropriate filters, and adhering to best practices, researchers can effectively remove spores from liquids and air, ensuring the integrity of their experiments and the safety of their work environment.
Understanding the Halo of Spores: Mechanics, Effects, and Strategic Use
You may want to see also
Explore related products

UV Radiation Application: Utilizing UV light to damage spore DNA and prevent replication
UV radiation, particularly in the UVC range (200–280 nm), is a potent tool for decontaminating spores in laboratory settings. Its effectiveness stems from its ability to penetrate the spore’s outer coat and damage the DNA, rendering it incapable of replication. Unlike chemical methods, UV radiation leaves no residue and is environmentally friendly, making it a preferred choice for sensitive lab environments. However, its success depends on precise application, as factors like exposure time, intensity, and distance from the UV source significantly influence efficacy.
To implement UV radiation effectively, follow these steps: first, ensure the UV lamp emits UVC light at a wavelength of 254 nm, the most effective range for DNA damage. Position the lamp at an optimal distance from the contaminated surface, typically 15–30 cm, to balance intensity and coverage. Exposure time varies depending on the spore type and UV intensity, but a common guideline is 30–60 minutes for thorough decontamination. For example, *Bacillus subtilis* spores require approximately 40 minutes of exposure at 1 mW/cm² to achieve a 99.9% reduction. Always pre-clean surfaces to remove debris, as organic matter can shield spores from UV light, reducing effectiveness.
While UV radiation is powerful, it is not without limitations. Spores in crevices or shaded areas may remain unaffected, necessitating thorough surface preparation and possibly multiple exposures from different angles. Additionally, prolonged UV exposure can degrade certain materials, such as plastics and textiles, so compatibility with lab equipment must be considered. Regularly monitor UV lamp intensity using a radiometer, as bulb output decreases over time, compromising decontamination efficacy.
A comparative analysis highlights UV radiation’s advantages over alternatives like autoclaving or chemical disinfectants. Unlike autoclaving, UV treatment does not require heat or moisture, making it suitable for heat-sensitive materials. Compared to chemicals, it avoids the risk of corrosion or toxicity. However, UV’s line-of-sight limitation means it cannot replace comprehensive decontamination protocols but rather complements them. For instance, combining UV treatment with a brief chemical wipe-down can address both surface and shadowed spores.
In conclusion, UV radiation is a precise and residue-free method for decontaminating spores in labs, but its success relies on careful execution. By adhering to specific dosages, ensuring proper positioning, and accounting for limitations, researchers can effectively harness UV light to safeguard their environments. Regular maintenance and integration with other methods maximize its utility, making it an indispensable tool in spore decontamination protocols.
Understanding the Lifespan of Fern Spores: How Long Do They Last?
You may want to see also

Incineration Procedures: Burning contaminated materials to completely destroy spores and prevent spread
Incineration stands as one of the most effective methods for decontaminating spores in a laboratory setting, offering a near-absolute guarantee of destruction. This process involves exposing contaminated materials to temperatures exceeding 800°C (1472°F) for a minimum of 30 minutes, ensuring that even the most resilient spores are eradicated. Unlike chemical or autoclave methods, incineration leaves no viable biological material behind, making it ideal for high-risk pathogens like *Bacillus anthracis* or *Clostridium difficile*. However, its effectiveness hinges on proper execution, including the use of specialized incinerators designed to handle biological waste and prevent aerosolization of spores during burning.
The procedure begins with careful segregation of contaminated materials, which should be placed in leak-proof, combustible containers labeled with biohazard symbols. These containers are then transferred to a dedicated incineration facility or on-site incinerator equipped with secondary combustion chambers and air pollution control systems. Operators must wear personal protective equipment (PPE), including heat-resistant gloves and respirators, to minimize exposure to fumes or residual particles. Once loaded, the incinerator is preheated to the target temperature before ignition, ensuring rapid and complete combustion. Monitoring systems should confirm that the internal temperature remains consistent throughout the process, as fluctuations can compromise spore destruction.
While incineration is highly effective, it is not without limitations. The method is resource-intensive, requiring significant energy input and specialized equipment, which may not be feasible for all laboratories. Additionally, incineration produces ash and emissions that must be managed to comply with environmental regulations. Laboratories must install scrubbers or filters to capture particulate matter and neutralize toxic gases before release into the atmosphere. Despite these challenges, incineration remains the gold standard for spore decontamination in high-containment facilities, where the risk of contamination outweighs the operational costs.
A critical aspect of incineration is its role in preventing the spread of spores beyond the laboratory. Unlike autoclaving or chemical disinfection, which may leave behind spore fragments or toxins, incineration reduces contaminated materials to sterile ash, eliminating any risk of recontamination. This makes it particularly valuable during outbreak scenarios or when handling unknown pathogens. For example, during the 2001 anthrax attacks in the United States, incineration was the primary method used to decontaminate mailrooms and laboratories exposed to *Bacillus anthracis* spores, effectively halting further transmission.
In conclusion, incineration procedures offer a definitive solution for spore decontamination in laboratory settings, combining unparalleled efficacy with stringent safety measures. By adhering to best practices—such as proper waste segregation, temperature monitoring, and emissions control—laboratories can ensure complete spore destruction while minimizing environmental and occupational hazards. While not suitable for all situations, incineration remains an indispensable tool in the biosafety arsenal, particularly for high-risk pathogens where no margin for error exists.
Exploring Non-Destructive Spore Drive Technology: Fact or Fiction?
You may want to see also
Frequently asked questions
The most effective methods include autoclaving at 121°C for 30 minutes, chemical disinfection with spore-specific agents like bleach (5-10% sodium hypochlorite), or using dry heat sterilization at 160-170°C for 2 hours.
Yes, spores are highly resistant to standard disinfection methods. They require specialized procedures like high-temperature autoclaving, prolonged exposure to strong chemicals, or dry heat sterilization to ensure complete decontamination.
All equipment should be treated as contaminated. Autoclave reusable items before cleaning or disposal. For non-autoclavable items, use spore-specific disinfectants and follow manufacturer guidelines for contact time and concentration.
Use dedicated equipment and workspaces for spore-related experiments, wear appropriate PPE, and follow strict aseptic techniques. Regularly decontaminate surfaces and equipment, and ensure proper waste disposal through autoclaving before removal.

























